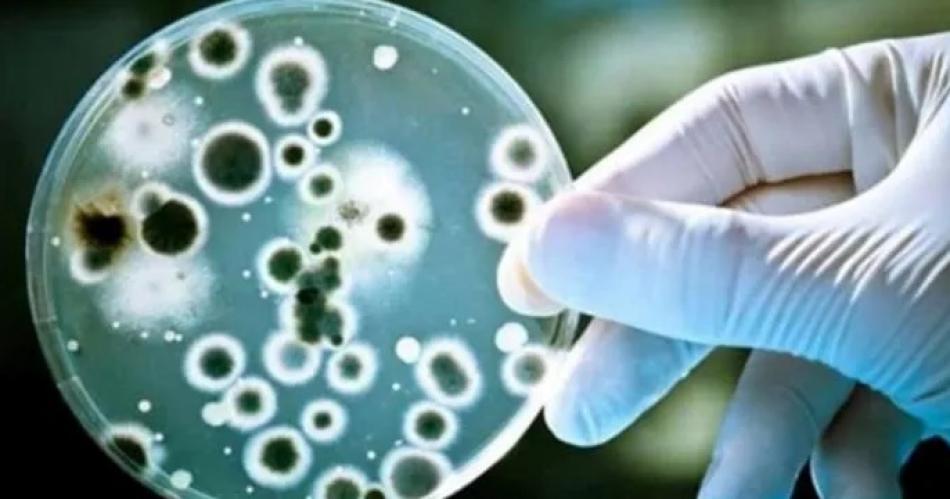
De queacute se trata la enfermedad que afecta a turistas que veranean en las playas brasilentildeas punto por punto

De qué se trata la enfermedad que afecta a turistas que veranean en las playas brasileñas, punto por punto De qué se trata la enfermedad que afecta a turistas que veranean en las playas brasileñas, punto por punto
¿Qué es la gastroenterocolitis?
"Es una inflamación del estómago, intestino y el colon que puede deberse a causas de tipo infecciosas o no infecciosas", explica Francisco Dadic, médico toxicólogo y presidente de la Fundación Argentina de Toxicología en diálogo con La Nación. En el caso de las infecciosas, señala, se asocian habitualmente a distintos patógenos como bacterias, virus y parásitos. Uno de los casos más frecuentes que destaca es el de la Escherichia coli (E. coli), una bacteria que se encuentra en la materia fecal y en lugares donde hay agua estancada.
También te puede interesar:
¿Es la gastroenterocolitis contagiosa?
Romina Fischman, médica gastroenteróloga y experta en salud digestiva integral, sostiene: "En el caso de Brasil, si se confirma que el origen es el agua contaminada, se debe procurar hacer todo con agua segura como por ejemplo, cepillarse los dientes o bañarse con agua mineral".
¿Cómo tratar un cuadro de gastroenterocolitis?
En primera instancia e independientemente de la gravedad del cuadro, con abundante hidratación. Una vez que se acude a la consulta, el médico puede indicar tratamiento sintomático, es decir, específico para revertir síntomas.